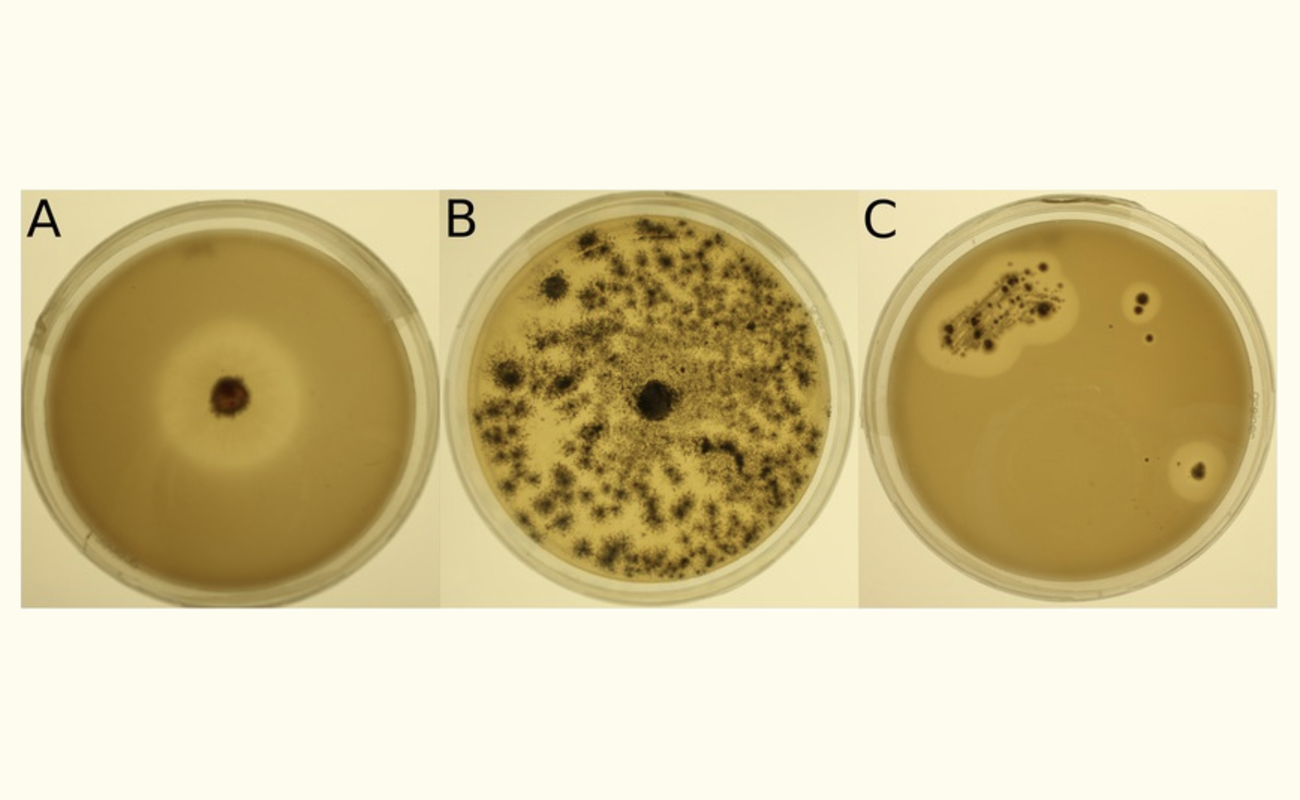

The Four Phases of Plastic Biodegradation
Plastic biodegradation is a complex process that occurs in active microbial environments such as landfills, oceans, and soil. These environments contain thriving fungal and bacterial colonies that can colonize and digest polymers. The biodegradation process of plastics treated with organic additives, like those developed by Biodegradable Future, occurs in four distinct phases.
Phase 1: Aerobic Phase
The aerobic phase typically lasts for the first few days of the biodegradation process[1]. During this initial stage:
– Aerobic microbes begin to establish themselves in the environment.
– Moisture starts to accumulate in the refuse.
– The organic additive causes swelling of the plastic, weakening polymer bonds.
– Molecular spaces are created, allowing for rapid microbial growth and the initiation of aerobic degradation.
– Oxygen is gradually replaced with carbon dioxide.
Phase 2: Anaerobic Non-Methanogenic Phase
This phase usually occurs from about two weeks to six months after disposal. Key processes during this stage include:
– Anaerobic processes begin as oxygen levels decline.
– Hydrolysis occurs, where microbe colonies consume particulates and enzymatically reduce large polymers into simpler monomers.
– The organic additive causes further swelling and opening of the polymer chain, increasing quorum sensing.
– Acidogenesis takes place, converting simple monomers into fatty acids.
– Carbon dioxide production increases rapidly.
Phase 3: Anaerobic Methanogenic Unsteady Phase
This phase typically spans from 6 to 18 months. During this period:
– Microbe colonies continue to grow and consume the polymer chain.
– Increasingly larger molecular spaces are created.
– Acetogenesis occurs, converting fatty acids into acetic acid, carbon dioxide, and hydrogen.
– Carbon dioxide production rates begin to decline.
– Hydrogen production eventually ceases.
Phase 4: Anaerobic Methanogenic Steady Phase
The final stage of decomposition lasts from 1 to 5 years. In this phase:
– Methanogenesis takes place.
– Microbes continue to consume the remaining polymer surface.
– Acetates are converted into methane and carbon dioxide.
– Hydrogen is consumed.
– The process continues until only humus remains.
– This nutritional soil enhances the environment for microbes and facilitates the final stages of decomposition.
Conclusion
It’s important to note that this biodegradation process requires an active microbial environment. Suspended or dormant environments, such as offices, warehouses, and retail stores, do not provide the necessary conditions for biodegradation to occur.
The use of organic additives, like those developed by Biodegradable Future, can significantly enhance the biodegradation process of plastics in these active microbial environments. These additives are designed to be integrated into the production of polymers, plastics, and textiles, enabling them to biodegrade once they reach end-of-life environments.
By understanding and harnessing these four phases of biodegradation, we can work towards more sustainable plastic solutions that minimize long-term environmental impact. However, it’s crucial to remember that while biodegradable plastics offer a promising solution, proper disposal in environments that support active microbial activity is essential for effective biodegradation.
Learn More About Biodegradable Future
Are you interested in sustainable plastic solutions? Discover how Biodegradable Future’s innovative additives can revolutionize plastic biodegradation. Our EU and FDA compliant technology accelerates the natural breakdown process, turning plastics into nutrient-rich soil.
Take action today:
- Explore our range of biodegradable additives
- Request a product demonstration
- Join the movement towards a cleaner, greener future
Contact us now to learn how Biodegradable Future can help your business reduce its environmental impact while maintaining product quality and performance.